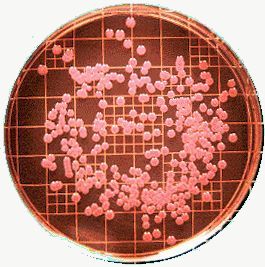
Pinkish colonies of Enterobacter aerogenes growing on MacConkey agar
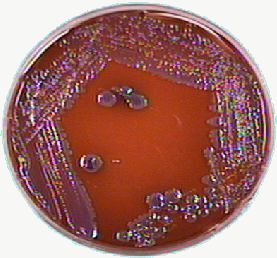
Mucoid-looking almost iridescent Enterobacter aerogenes growing on EMB agar

Fig 1.
Fig 2.

Fig 3.
Although sometimes regarded as rather worrisome pathogens, Enterobacter species are not necessarily all bad. Not often a problem in healthy individuals, they are opportunistic pathogens in people with precarious immune systems, especially in hospitals where infection control has broken down.
Enterobacter cloacae has been used in biological control of plant diseases (notably the seed-rotting oomycete Pythium ultimum). Transgenic (aargh!?) E. cloacae have been used to control insect pests on mulberry leaves [J Appl Microbiol 2000 Jan;88(1):90-97].
Enterobacter infections are becoming more common in intensive care. They are mainly found where:
Enterobacter infection has also been traced to contaminated albumin concentrates (yet another reason not to use albumin), prefilled saline syringes, multidose vials and contaminated infant formulae (in the tin), with consequent necrotising enterocolitis. [J Clin Microbiol 2001 Jan;39(1):293-297] Total parenteral nutrition solutions have been contaminated during preparation. Haemodialysis machines with defective waste-handling ports have also been responsible for haematogenous infection. Strains have even been found that can grow in drinks containing methylparaben (and will even grow in concentrations of 3000mg/L)! Enterobacter meningitis in adults has been reported following neurosurgery, presumably consequent on the usual predisposing causes!
These have been poorly studied. See [J Antimicrob Chemother 1998 Mar;41(3):367-72] for some data on aerobactin production, haemagglutinins (mannose-sensitive), and resistance to serum bactericidal activity. A haemolytic leukotoxin has been reported [Biochem Biophys Res Commun 2000 Aug 11;274(3):649-654].
A member of the family 'Enterobacteriaceae' (but not the 'type genus' - this dubious honour belongs to Escherichia), Enterobacter can more-or-less be identified if you encounter large lactose-fermenting colonies of Gram negative rods, that are either raised or mucoid . The only important confounding bug is Klebsiella, which is similar (and closely related) - admittedly, Hafnia alvei is similar, but is rarely a cause of disease in man. Serratia marcescens doesn't ferment lactose.
We can often distinguish Enterobacter from Klebsiella by seeing whether the organism is motile - if it is, it must be Enterobacter (although some are immotile). Enterobacter can also decarboxylate ornithine, something Klebsiella cannot do.
Enterobacter strains are mainly fimbriate and slime-forming.
(
Also citrate +ve, generate gas from glucose, ferment sucrose, arabinose,
mannitol, melibiose, raffinose, rhamnose, trehalose, and xylose. Most
are DNAse, indole, H 2 S and phenylalanine deaminase negative).
Eosin methylene blue (EMB) agar is selective for gram negative bacteria. Enterobacter and Klebsiella form large mucoid colonies that are pink to purple because of their lactose fermentation. They don't have the metallic sheen of E. coli. On MacConkey agar lactose fermentation results in a red colour.
Here are some pictures off the web:
|
|
|
|
| |
Fig 1. shows the red colour developed on MacConkey agar, Fig 2. the organism growing on EMB agar, which you may contrast with Fig 3. where you can see the greenish sheen of E. coli. The References section gives the web sources of the pictures!
There are several Enterobacter species, but E. cloacae and to
a lesser degree, E. aerogenes,
are the commonest pathogens. E. sakazakii (which forms bright yellow
colonies) is less common, but a nasty cause of neonatal sepsis, and
especially, meningitis, with brain abscesses, marked ventriculitis, and
hydrocephalus as a frequent consequence.
The rather unusual 'E. agglomerans' is now known as Pantoea agglomerans (also once called Erwinia milletiae) - it
may cause infection in ICU and has also been invoked as the cause for
"cotton fever" - encountered where intravenous drug abusers filter their
heroin with cotton!
(Other species are E. amnigenus, asburiae,
cancerogenus* [=taylorae =cancerogena =CDC enteric group 19], dissolvens, gergoviae,
hormaechei [=CDC enteric group 75], intermedius [=intermedium],
kobei [=NIH group 21],
nimipressuralis, and pyrinus*, possibly even 'cowanii' [=NIH group 42];
*=plant pathogens).
Different species of Enterobacter are differentiated by their ability to ferment particular sugars, and possession of arginine dihydrolase, lysine and ornithine decarboxylase.
Carbapenems are at present probably the treatment of choice, although cefepime may be used. Quinolone sensitivity is variable, and resistance may develop during treatment (this can also occur with carbapenems). Some organisms are sensitive to co-trimoxazole.
Note that some advocate combination chemotherapy for E. cloacae infection.
Resistance to everything apart from carbapenems (imipenem, meropenem) and possibly quinolones is common. Some recommend that quinolones not be used owing to emergence of resistance during therapy. In fact, resistance to carbapenems may also emerge. Patterns and rates of resistance vary greatly between antibiotics
Do NOT use first, second or third generation cephalosporins as they are often ineffective, and resistance commonly appears, especially in units where cross-infection is common, and use of these agents is widespread. Cefepime resistance is not at present a major problem, so this is another option. (Cefepime and cefpirome resistance is now well-documented, related to massive production of a modified cephalosporinase [FEMS Microbiol Lett 2001 Feb 20;195(2):185-190] ).
Amp-C (stably derepressed) cephalosporinases are commonly present.
ESBL resistance may be transferred from Enterobacter to E. coli
E. cloacae resistance to carbapenems has been reported related to a combination of:
Occasional resistance to carbapenems may be due to production of zinc metallo-proteinases (e.g. IMP-1), or rarely 'Ambler class A' beta lactamases (E. cloacae strain NOR-1).
As expected, mutations in DNA gyrase confer fluoroquinolone resistance - a single point mutation is enough.
Avoid the use of first, second or third-generation cephalosporins, as these may predispose to Enterobacter infections. Hand-washing is still the most important way to prevent Enterobacter infection.
Many references are embedded in the HTML text (Click View | Source in your browser).
We briefly discussed Enterobacter in our antibiotic therapy in ICU web-page.
The pictures above came from:
 http://endeavor.med.nyu.edu/courses/microbiology/courseware/infect-disease/Gram_Neg_Bacilli5.html) which
is an impressive and extremely well-illustrated page on identification of Gram-negative bacilli.
http://endeavor.med.nyu.edu/courses/microbiology/courseware/infect-disease/Gram_Neg_Bacilli5.html) which
is an impressive and extremely well-illustrated page on identification of Gram-negative bacilli.
 http://www.cat.cc.md.us/~gkaiser/labmanua/lab3/lab3.html)
http://www.cat.cc.md.us/~gkaiser/labmanua/lab3/lab3.html)
| Date of First Publication: 2001/9/29 | Date of Last Update: 2006/10/24 | Web page author: Click here |